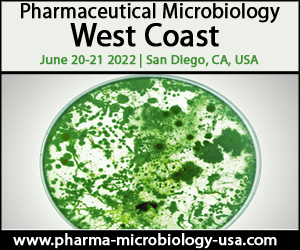
5th Pharmaceutical Microbiology West Coast Conference

Sponsored by: Associates of Cape Cod, Bioscience International and Ecolab Assuring end-patient safety through holistic contamination control Conference Chairman: Don Singer, USP General Chapter Committee, Microbiology Chair, US Pharmacopeia and ECOLAB Following on the success of the previous West Coast events, we are delighted to announce the 5th Annual Pharmaceutical Microbiology West Coast conference taking place in San Diego on June 20th and 21st,2022. Microbiology remains an essential tool for the detection of microorganisms to protect patients globally. The pharmaceutical microbiology industry has seen many changes during the progression into the 21st century. With advances in rapid microbiological methods, revised industry regulation, enhanced knowledge of innovative therapies, and novel testing methods, this industry is ever expanding. This conference will explore the most pressing topics in this thriving field, from the movement toward process automation and minimisation of operator intervention, to the latest technologies in rapid microbiological testing methods and data integrityJoin industry experts to discuss the latest topics and pressing challenges in this field. Network with professionals, discuss revisions in regulatory and guidance documents, explore data integrity considerations and approaches for conventional and rapid microbiology methods, discuss optimised environmental monitoring to best control contamination and gain insight into an industry perspective on alternative endotoxin testing methods and process automation, all contributing to better management of contamination in biopharmaceutical manufacturing. Key Reasons to Attend:1. Discuss expert guidance and explore the regulations concerning objectionable organisms in drug products2. Gain insight into changing paradigms in the field, from in-process testing to digitalisation3. Explore alternative endotoxin test methods and rapid microbiological testing4. Evaluate the best practices and most common pitfalls within microbial detection and elimination5. Dissect the framework of a robust Global Contamination Control Program and how to approach implementing a holistic CCS Interactive Post Conference Workshop June 22, 2022 Cleanroom Qualification-Common MisstepsWorkshop Leaders: Ziva Abraham, President, Microrite and Morgan Polen, SME Cleanroom Contamination Control, Microrite Who Should Attend:Senior Microbiologist, Lead Scientist, Laboratory Manager, QA Specialist Drug Substance External Manufacturer, Business Development Manager - Testing, Pharmaceutical Microbiology Consultant, Higher Pharmacopoeia Scientist, Analytical Standards Specialist URLs:Tickets: https://go.evvnt.com/1034729-2?pid=5569 Exhibitor: https://go.evvnt.com/1034729-5?pid=5569 Inquiries: https://go.evvnt.com/1034729-6?pid=5569 Sponsor: https://go.evvnt.com/1034729-7?pid=5569 Date and Time: On Mon, Jun 20, 2022 ( 8:00 AM) - Tue, Jun 21, 2022 ( 6:00 PM) Venue details: Hyatt Regency Mission Bay Spa And Marina, 1441 Quivira Road, San Diego, California, 92109, United States Prices:Conference only: USD 1999.00,Conference and 1 Workshop: USD 2498.00,Workshop Only: USD 499.00